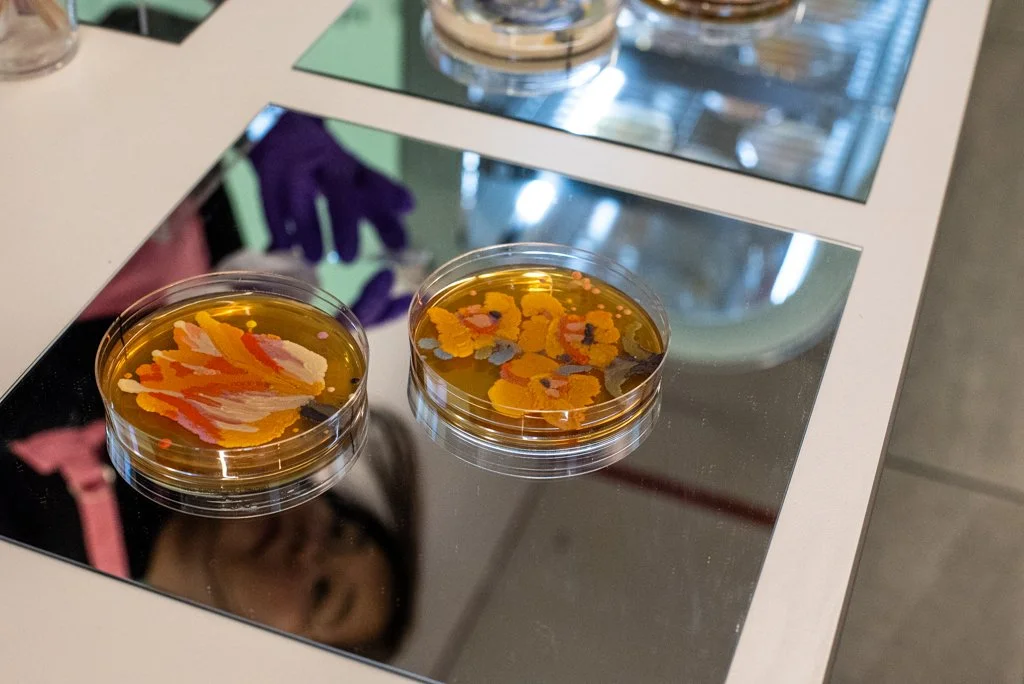

Current Exhibition
WATER STORIES
Opening Reception: June 8, 2024, 5:00 PM - 8:00 PM
Closing Date: Saturday, May 3, 2025
Curated by: Elena Soterakis
Exhibiting Artists: Anne Hollænder, Arantxa Araujo, Christopher Lin, DB Lampman, DLX Design Lab, Edrex Fontanilla, Elizabeth Hénaff, Heather Parrish, Keren Anavy, Léonard Roussel, Nathan Kensinger, Ranjit Bhatnagar, Sara Kostić, Sarah Nelson Wright, Seth Wenger, Yan Shao, and Yoko Shimizu.









































Water Stories invites audiences to immerse themselves in the poetic essence and ecological significance of water. The exhibition highlights stories of our local waterfronts, coastlines and waterbodies and places them in conversation with global narratives, historical legacies, and imagined futures.
Through a blend of immersive multi-sensory installations and interactive artworks, this exhibition encourages a reflective journey and underscores the critical importance of water in all our lives.
In addition to works presented in the gallery, Water Stories features a year of public programs and community engagement activities. These events aim to strengthen our connection to local waterfronts and inspire us all to be citizen scientists. By fostering meaningful dialogue around the stories and experiences of water, we hope the exhibition will cultivate reverence for the natural world and strengthen our bonds with global waterfront communities.
This curation is inspired by the essential work and dedication of our upstairs neighbors at the Interstate Environmental Commission (IEC). Founded in 1936, the IEC monitors the ecological health of our shared waterways in New York, New Jersey, and Connecticut through collaborative water quality monitoring projects funded by federal, state, and local agencies.
Special thanks to our partners:
Interstate Environmental Commission, The United States Environmental Protection Agency, BioBAT Inc., University of Tokyo, New York University, SUNY Downstate, the New York Economic Development Corporation, Evelyn Powers, Tom Hall, Doug Chapman, Alvaro Azcarraga, and Eve Barro.
Past Exhibition
Embodied Futures & the Ecology of Care
Opening Reception: Saturday, October 14, 2023, 5–7 pm
Closing Date: Saturday, March 16, 2024
Curated by: Elena Soterakis & Eve Barro
Exhibiting Artists: Aradhita Ajaykumar Parasrampuria, Katie Hubbell, Elaine Young, Karen Ingram, Laura Kung, Juyon Lee, Lolo Ostia, John Roach, Iz Nettere, Shihori Yamamoto, Suzanne Head

Embodied Futures & the Ecology of Care invites the viewer to reimagine “care” as a dynamic, flowing force that sustains and nurtures all beings as opposed to being a gift bestowed across a hierarchical power gap.
In a transforming world propelled by exponential advancements in technology and shifting ecological paradigms, the interdisciplinary art presented here serves as a bridge to a future where post-humanist ethics flourish and care becomes a womb-like embodiment woven through the fabric of existence.
This exhibition is a convergence of art, biology, technology, and ethics, which invites us to re-envision our relationship with the living world and ask the fundamental question: How can the concept of care be expanded beyond the human sphere?
The concept of "embodied futures" takes on new dimensions in this context. It speaks to a future where bodies, ecologies, and technologies merge, blurring the lines between self and environment. As we stand on the precipice of a new era, these works urge us to consider how our actions today shape the political and ethical, and ecological landscapes of tomorrow — landscapes in which care, empathy, and reciprocity are currencies that bridge the gaps between species and worlds.
With Special Thanks to Co-Organizers: Clarinda Mac Low & Carolyn Hall of Genspace, Junho Lee & Katherine Plourde of NARS Foundation, and DB Lampman of Makerspace
This exhibition is made possible by the collaborative efforts of Genspace, NARS Foundation, Makerspace, Sunset Park Open Studios BioBAT Inc., SUNY Downstate, the Brooklyn Army Terminal, and the New York Economic Development Corporation.